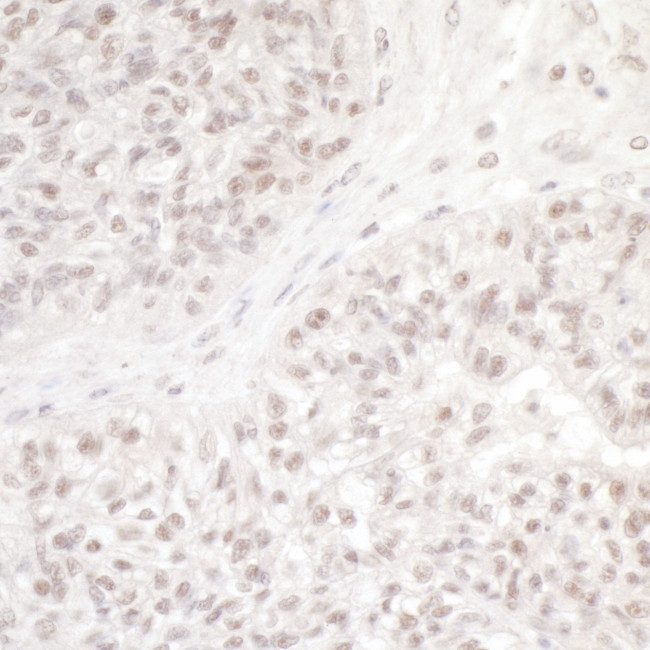
DC8 Antibody in Immunohistochemistry (Paraffin) (IHC (P))

Search
Bethyl Laboratories
DC8 Polyclonal Antibody
{{$productOrderCtrl.translations['antibody.pdp.commerceCard.promotion.promotions']}}
{{$productOrderCtrl.translations['antibody.pdp.commerceCard.promotion.viewpromo']}}
{{$productOrderCtrl.translations['antibody.pdp.commerceCard.promotion.promocode']}}: {{promo.promoCode}} {{promo.promoTitle}} {{promo.promoDescription}}. {{$productOrderCtrl.translations['antibody.pdp.commerceCard.promotion.learnmore']}}
产品信息
A300-794A
种属反应
宿主/亚型
分类
类型
抗原
偶联物
形式
浓度
规格
纯化类型
保存液
内含物
保存条件
运输条件
产品详细信息
The recommended shelf life for this product is 1 year from date of receipt.
Application Note: For IHC, epitope retrieval with citrate buffer pH 6.0 is recommended for FFPE tissue sections.
靶标信息
Part of the MIS12 complex which is required for normal chromosome alignment and segregation and kinetochore formation during mitosis.
仅用于科研。不用于诊断过程。未经明确授权不得转售。
篇参考文献 (0)
生物信息学
蛋白别名: Kinetochore-associated protein NSL1 homolog; NSL1, MIND kinetochore complex component, homolog; NSL1, MIS12 kinetochore complex component; unnamed protein product
基因别名: C1orf48; DC31; DC8; MIS14; NSL1
UniProt ID: (Human) Q96IY1
Entrez Gene ID: (Human) 25936